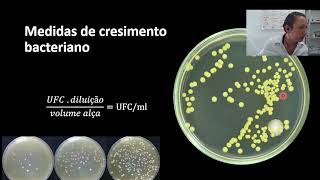

Provas Bioquímicas em Microbiologia
12.38k views6067 WordsCopy TextShare

Eduardo Garrido
Aula explanando a importância das prova bioquímicas para o diagnóstico microbiológico.
Video Transcript:
a gente foi lá então falar um pouquinho hoje a sobre provas bioquímicas em microbiologia na já tinha feito uma aula anteriormente que mostrava para gente um pouquinho sobre a utilização dos meios de cultura tá então quer dizer o meio de cultura e o crescimento da colônia é super importante para a gente fazer a identificação bacteriana mas às vezes não é a única coisa que resolve o nosso problema então às vezes a gente precisa um pouco mais do que isso porque tem colônias que são semelhantes que são parecidas aí a gente não pode confiar também só
no critério né então outra possibilidade além dos meios dos meios seletivos e tudo mais é o uso de algumas provas bioquímicas tá nós vamos realmente falar de algumas provas bioquímicas na realidade são várias são inúmeras né então não dá para a gente falar de todo mundo aqui mas é importante que vocês têm uma noção de para que que serve provas bioquímicas qual a sua função e na as principais conhecer e saber aí de acordo com a necessidade de vocês vocês vão procurar na mais faz provas que possam resolver a questão específica que vocês procuram então
já deixou claro que é óbvio que nós vamos falar de todas essas provas bioquímicas que existem ao celular apenas de algumas mais famosas e com certeza estou deixando alguma importante para trás isso é porque são muitas então tem bom tá mas vamos lá bom né as bactérias e pode ser identificadas além daquelas características que a gente já falou de crescimento no meio né do formato da sua colônia das características territoriais e gram-negativas gram-positivas se ela que se cora e em colorações [Música] ácido-resistentes né álcool-ácido resistentes também elas podem ser identificadas por características metabólicas o seu
metabolismo como a produção de alguns substrato específico ou a produção de gases então eu tenho na degradação por exemplo de carga de algum carboidrato então eu tenho bactérias que consomem glicose eu tenho outras que consomem sacarose outros que consomem lactose o contrato que consomem todas essas e aí eu consigo trabalhar isso de uma forma fazer uma identificação na bioquímica e ver o que que ela tá consumindo e essa é uma característica de qual bactéria tá e aí a gente já consegue fazer esse reconhecimento utilizam-se para isso meios de culturas seletivos ou em tecidos e também
reagentes específicos para detectar na para se detectar essas metabólicos em algumas provas mais conhecidas né aqui não são na verdade as provas mas os estilos né é só as provas que avaliam a utilização das fontes de carbono então basicamente né a utilização aí de provas a relativas ao uso de a glicose lactose né as contas de carbono e energia para as bactérias avalia também a utilização de fontes de nitrogênio tá ah e também nascer e pouco consegue reduzir nitrato e nitrito por exemplo na detecção da produção de enzimas específicas então eu quero ver se ele
consegue produzir por exemplo catalase e oxidase e uma série de outras enzimas e avaliação da motilidade bacteriana tá que a capacidade dessa bactéria se mover bom então vamos começar falando um pouquinho de teste de motilidade olha lá o teste de utilidade ele pode utilizar um tubo com um meio semi-sólido né no seu interior e que vai permitir um crescimento bacteriano por todo tu bom então sim dentro desse e-mail na todo tudo poderia ser a ser humano quando eu vou dizer difícil todas as bactérias podem crescer em todo o tudo bom que que vai depender se
essa bactéria cresce em apenas uma área específica do tubo ou se ele cresce no tubo inteiro a capacidade que essa bactéria tem de se mover então as bactérias imóveis elas vão turvar apenas a linha em que elas foram inoculadas basicamente o que eu faço né é pegar um um e o espeto mesmo que eu vou mergulhar no meu passar na minha colônia né e aí eu mergulho esse espeto né com a colônia no meu meio né como sim eu tivesse um frasco aqui e fizesse esse movimento né com o meu meu espeto zinho lá no
laboratório tá bom e aí eu fui ver como que vai turvar nesse meio então se ele turbo ou apenas na linha como está aqui neste frasco tá vendo que só aqui que ficou turvo o que significa que essas bactérias não tem a capacidade de se movimentar e pelo pelo meio claro que independente disso se eu mandei isso aqui né por muito tempo vários dias ele vai tomar o resto mas vai demorar porque ele vai ter que ir crescendo empurrando uma bactéria empurrando a outra aqui não há diferença como está turvando e não fica uma linha
clara né já estudou aqui já tem vou aqui já vou aqui aqui tá bem difuso a imagem né então essa imagem a gente vê que está tendo a movimentação da bactéria então isso aqui indica para mim que é a bactéria que aqui foi calculada é uma bactéria que tem utilidade é uma bactéria móvel portanto é uma bactéria flagelada tá então aqui eu tenho inoculação de uma bactéria flagelada e aqui ontem uma inoculação de uma bactéria não flagelaram bactéria imóvel este em alguns meios que nós podemos usar para fazer esse teste tá então mexo fato igual
motilidade e motilidade em do lisina motilidade indol permitir que esses são os produtos que eu vou utilizar né que não tão as fórmulas né mas isso tem facilmente a gente a gente encontra tá mas a gente vai produzir esse meio no laboratório para usar para fazer esse teste bom que a gente pode já comprar um e-mail já pronto outro teste bastante importante esse é bem legal simples muito simples de fazer e a bem legal tá o que a gente vai fazer a colocar né o teste de catalase a gente vai colocar uma gota de cultura
na líquida em uma lâmina e deposita-se sobre essa gota uma gota de peróxido de hidrogênio a três por cento fica peróxido de hidrogênio o oxigenador então eu vou diluir a água oxigenada que vem por exemplo quando a gente compra o laboratório ela tá trinta por cento então a gente faz uma diluição disso a e diluir para três por cento tá eu posso em vez de ser uma gota também de uma cultura ali que eu já pegar um fragmento da minha colônia na e espalhar sobre a lâmina então se for uma colônia numa placa de petri
e eu recolho passa na lamy passa na lâmina né e aí eu coloco uma gota de água oxigenada sobre ela na presença da enzima catalase uber óxido de hidrogênio ele vai ser a destruído ele vai ser né catalagem é uma enzima que vai quebrar e o peróxido de hidrogênio em duas moléculas de água e uma molécula de oxigênio como tá aqui então a catalase quebra essa estrutura da água oxigenada formando água e oxigênio livre e esse oxigênio livre que vai fazer a produção de bolhas é por isso que o boxe que a água oxigenada faz
bolha tá e aí quem produzir bolo então é positivo e não é como a gente tá vendo aqui quem não produz bolha é negativo tá legal a ideia foi muito boa dá para gente diferenciar mais afinal de contas que produzem que não produz bom entre uma série de outras bactérias isso aqui é muito importante para a gente para a gente diferenciar os streptococcus que são negativos dos estafilococos e dos micrococcus que são positivos então essa teste muito usado na diferenciação então eu tenho lá minha colônia peguei a minha colônia faça uma semana faça a coloração
de gram vejo que eu tenho copos gram-positivos aline eu posso afirmar categoricamente que aqui não está fácil do que aquele estrépito que aquilo ao micrococcus não posso por mais que ele esteja arranjado né e se não tiver com um arranjo claro se ele estiver com um arranjo para a gente tiver várias a soltas bom então eu preciso ter certeza de quem tá ali então uma forma de fazer isso é a catalase bom então vou fazer o teste de catalase depois eu posso fazer um outro teste que o teste de oxidase e olha que legal então
aqui eu vou descobrir se a minha bactéria produz toxicidade ou não produz oxidantes bom a oxidase na presença de a presença desculpa a presença de se tocou oxidase que é a enzima né ela vai oxidar aceptores nade substratos na presença de oxigênio então o que acontece quando eu pego a minha mostra na a minha mostra com as minhas bactérias na membrana das bactérias em substratos que são aceptores for oxigenius bom e que na presença da citocromo oxidase do teste ele vai ficar marcando em roxo ok então quem marcar em roxo é pronto é ele é
positiva para produção de oxidase quem não marcar é negativo ok e a gente tem que na verdade ação positiva a lenta a gente não leva em consideração tá olhar positivo ou ele vai ser negativo porque ele tem um tempo né a gente tem que ver isso em até dois minutos tá bom depois disso a gente já não leva mais em consideração porque a marcação roxa pode vir de reações inespecíficas tá bom bom que que a gente vai ver micrococcus lei séria pseudomonas e bacilos gram-negativos não fermentadores de glicose comunello a prova que o seu de
hormônios no caso eles são positivo a chegar ou seja eles vão marcar em roxo aqui tá e as enterobactérias e os estafilococos eles são negativos e a gente usa basicamente isso aqui o que é um papel filtro em bebida em tetramethyl pé fenilenodiamina ah tá aqui normalmente é monohidratada ou de hidratada então a gente pode usar esse essa substância química né ela vai estar lá o já seca né no papel e quando a gente colocar é uma gota esfregão na ali da nossa colônia a colônia vai rapidamente né no prazo de dois minutos aí marcar
se ela é ou não positiva para produção de oxigênio fora o uso do tratamento super fenileno já mina nós podemos comprar um teste pronto que nada já mesma coisa diferença que o teste já vem pronto dentro prontinha para você usar né você só coloca ali uma gota da sua colônia e muito bem e não numa a para a cidade é muito grande você não precisa produzir o meio é o meio não né o reagente químico ou fazer as fitas de de papel filtro em beber elas e calas armazená-la tá trabalhando como você compra já pronto
facilita bastante a vida a mais um teste que é bastante importante bastante é bastante utilizado né ele é muito legal é um teste de coagulase para que que serve o teste de coagulase pó a enzima coagula na presença do plasma vai provocar a coagulação né sim né a bactéria produz coagulado e ah entendeu então a hora que eu colocar ela plasma de coelho com mta já liofilizados mesmo fato de telha gta ou a presença da bactéria que é coagulase positiva se a bactéria for coagulase positiva ela vai coagular tá bom então a gente tem daqui
duas bactérias staphylococcus epidermidis tá vendo como não coagulou o frasco do tubo ainda tá líquido e o staphylococcus áureos que fez um coágulo no no plasma de coelho então o plasma ou a gulou na presença da bactéria porque ela tem coagulase e aí quando você deita tubo o tubo não ele não vai derramar aqui se eu continuar virando vou derramar o líquido bom então ele serve principalmente para que eu consiga determinar e a partir disso a diferença entre está com os áureos de outros staphylococcus por que que eu quero diferenciar essa flor copo usar óleos
porque ele é clinicamente o mais importante ele é extremamente fotogênico tá então eu preciso muitas vezes eu quero saber se é ele que está presente naquela região e aí ele que tá causando lesão tá porque eu tenho um monte de staphylococcus que estão aqui andando comigo estão na minha na minha flora bacteriana na pele anos rosas então vai ter mas quem que está lhe causando lesão também não é porque o staphylococcus áureos é o mais patogênico que ele é o único que vai causar lençol é só que por exemplo ele tem uma relação com antibióticos
mais complicadas a gente já tem muitos estados no copos que são resistentes a antibióticos então é importante a gente saber com quem a gente está lidando para a gente ver qual é a melhor abordagem terapêutica então de repente se eu for não está xococoho saurus eu tenho que me preocupar com antibiótico um pouco mais específicos foram staphylococcus epidermidis menos resistente menos problemático que a chance de lhe causar uma lesão mais séria é menor talvez eu possa não não usar um primeiro momento um antibiótico então potente o mais moderno eu posso usar um antibiótico um pouco
mais a simples é um amoxicilina por exemplo é não sabe colocar o óculos a horas talvez amoxicilina já não faça mais o som exemplo não estou dizendo que é isso que tem que usar nem que não é isso que deve usar somente um exemplo aleatório tá cada situação clínica na situação clínica e quem vai decidir o antibiótico que leva que deva ser usado é o médico ou veterinário ou odontológico com quem a rolar continuando a e como fazer um pauzinho aqui para a gente pensar tá então você já tem subsídios aqui para imaginar um caso
clínico vamos imaginar que você não é até a seguinte situação na mão vocês vão uma bactéria no meio agar nutriente né que é um meio agra bastante inespecífico e depois o seguiam que essa mesma bactéria cresceu no ar dela no agora bar de papel né que que é um água bard-parker pode pá que ele é seletivo para gram positivos então você já sabe que aquela bactéria cresceu no bairro de parque ela é gram-positiva se ela fosse gram-negativa ela nem tinha crescido tá então beleza você já tá começando a sua identificação aí você faz uma coloração
de gram e quando você faz a coloração de gram a partir daí do do meio do bate parque você viu que essas bactérias isoladas são copos então que a gente tem o gram-positivos tá ah eu gostaria do bar de paquera para descobrir isso não se você tivesse colhido conseguido isolar diretamente do agar nutriente você conseguiria fazer isso também na coloração de gram tá mas a gente tem a possibilidade vamos usar o barco parker vamos usar os a dar uma com o que ia assim por diante vamos lá achei então coccus grampositivos após isso eu quero
saber mais quem que é esses copos e eu posso ter ali vários corpos diferentes então eu posso imaginando né a possibilidade de ter uma cultura de estreptococos estafilococos ou de micrococcus e quem é como é que eu vou terminar quem que é essa bactéria que tá ali presente então vou fazer outros testes e os testes bioquímicos meu teste de catalase deu positivo se o teste de catalase deu positivo quem eu posso descartar se você já deve estar apto sair para imaginar quem que você pode despertar eu já sei aí eu fiz o teste de oxidase
o teste de oxidase deu negativo se o taxa de oxidação meu deu negativo eu também posso descartar alguém o descarte ah ah então tá então eu sei que eu já tenho tipo específico de bactérias que está ali né pelo menos um gênero a gente já fechou e às vezes não dá para gente saber mais do que isso mas às vezes dá neste caso eu posso fazer um teste de coagulase e o meu teste de coagulase deu positivo então a minha bactéria coagulou o plasma de coelho utilizado ali que eu coloquei então é positivo quem que
é essa bactéria e a gente já sabe que ela staphylococcus áureos para a gente já tem capacidade de avaliar isso gente honestamente e se vocês entenderam e da aula de meios de cultura da aula de bioquímica microbiológica até agora que o uso todos esses testes para chegar a este diagnóstico o que eu vou fazer isso de várias formas diferentes para chegar em diagnósticos de bactérias diferentes pronto vocês entenderam que deveria ser entendido é isso que vocês vão saber é óbvio que não quero que vocês decorrem né vocês não vão decorar todos os protocolos de todos
os testes para todas as situações porque isso é desnecessário não há a menor necessidade de você decorar isso tudo oi gente do céu hoje você resolve isso com um celular na mão tá se você tiver acesso à internet você resolve se você não tiver você vai carregar o livro de microbiologia na sua mochila é mas pelo amor de deus não é né ficar guardando todos os protocolos na cabeça de vocês não há necessidade então vocês entenderam o que eu faço esses testes bioquímicos para aí separando-se o meu teste de catalase tivesse dado negativo né eu
já tinha descoberto pelo streptococcus e não precisava fazer os outros testes se o teste de oxidase tivesse dado positivo e eu já sabia que era um micro focus ah tá depois eu ia tentar lá diferenciado da lei séria bom mas já saberia que não é o estrépito nem está frio tá se o teste de coagulase desce positivo eu já saberia que não é um saco copos áudios eu também não sei como dizer se é o intermédios se é a em santa médio intermédios né qual qual seria mas eu já sei que não é a luz
que é o que mais lhe importa está descobrindo tá bom então é isso que você só sabe mas vamos lá vamos conhecer mais alguns testes vamos saber mais alguns que estão interessantes para você saber em que existem sobre essas funcionam de formas diferentes um eu tenho por exemplo teste de hidrólise de gelatina o teste de hidrólise gelatina ele vai determinar a habilidade que a minha bactéria tem de produzir enzimas proteolíticas que vão hidrolisar a gelatina do meio então eu tenho um meio gelatinoso que eu coloco a minha bactéria né inocula bactérias a bactéria produz enzima
proteolítica o líquido a gelatina vai se like vai fazer ela vai hidrolisar ou seja vai se lhe pode fazer então a gente vê aqui no cê desculpa eu tô marcando com o dedo né quando se vocês pudessem ver bom vamos lá a minha gelatina aqui no itens e aí vocês conseguem ver que ela ficou lhe perfeita tá então ela é positiva o item ar não o item a ele é negativa ele tá certinho que ele continua gelatinoso e ele tem medo também parece que ficou lindo é feito né mas você tá bem claro então uai
negativo para igual a gelatina o meio ser positivos o que que ele vai identificar bastonetes gram-negativos não fermentadores de glicose como por exemplo pseudomonas e também ele serve para identificar a presença de construída perfringens a então eu fiz o teste de hidrólise de gelatina e deu positivo quem que é a pode ser pseudomonas ou pode ser costurinha perfringens além da pseudomonas tem um monte de outros bastonetes gram-negativos não fermentadores tá e não é o único alguns mais famosos mas está longe de ser o único aí eu gostei já perprint então como que eu sei quando
você sabe aí simples né se você pegou a sua colônia você faz uma coloração de gram se for um grande negativo não fermentador de glicose ele vai se curar na forma de um pastor net gram negativo ou seja vasco horário em rosa e vermelho e se ele for não conseguiu perfringens ele vai ser um bastonete gram positivo você já sabe que ele é um bastonete gram positivo a mãe vai te curar em roxo com azul e o teste de vermelho de metila a vanessa avalia então a valência as bactérias produzem ácidos a partir da fermentação
da glicose pela via ácido misty lista ácida mista desculpa então aqui ó a gente vê no centro o vermelho de metila como ele vem né quando a gente prepara ele tá desse jeito aí eu coloco a minha colônia se a linha colônia faz suplementação de glicose né o ph vai começar a diminuir porque ele está fermentando e produzindo ácido a partir da fermentação da glicose o o bh começa a cair e quando ph passar de 4,4 baixar a menos que 4,4 o meu meio vai ficar vermelho ele vai ficar mais ah não então tá laranja
a gente vai ficar avermelhado isto é indicativo da presença de cole daí esse dali séria tá se ele não fermenta a essas bactérias o ph tende a subir e aí o ph quando ele passar de seis provavelmente vai ser ação da crise ela dá inteiro baxter e de bacilos gram-negativos não histéricos né aí collier sim elas são bacilos gram-negativos mais internos isso não enquete e aí e o exame de box lojas pros flower trouxe calor desculpa é um nome complicadinho lojas postal ele vai avaliar a fermentação da glicose produzindo acetoína oi tá butileno glicol e
outras pequenas quantidades de ácido então se produziu acetona quando eu adiciona o cauã né hidróxido de potássio junto com o oxigênio atmosférico isso vai oxidar acetoína transformado acetoína em diacetil aí quando eu adiciono lu o alfa naftol tá ele vai catalisar né ele vai reagir com o diacetil então e ele vai reagir com diacetil escuta e vai produzir um anel vermelho tijolo em torno de 10 a 15 minutos a partir do momento em que se colocou só a gente tá então este é o teste positivo com esse anel vermelho esse é o teste negativo quem
que é positivo para dizer ela pneumoni enterobacter estafilococos e ensine a inter o lítica 25 listéria monocytogenes in oi nicole negativa micrococcus a negativa yersinia enterocolitica 37 gente é a mesma bactéria é a mesma bactéria mas são sempre diferentes esta cepa é negativa esta seca positivo tá feliz e ela e nos espera mar escreva o mate é a mesma bactéria não são do mesmo gênero mas são de espécies diferentes essa mesma espécie porém cepas diferentes ok e aí e alguns outros testes já estamos terminando aqui o teste de indol tá então o indol ele é
produzido a partir do triptofano que eu vou ter a nossa então o idol ele pode ser detectado pela formação de um anel rosa na parte superior do tubo após a adição do reativo de eric esse relativo ele age com o indol tá então lá no meio de cultura que eu fiz eu tinha o triptofano é sim a minha bactéria produzir uma enzima que chama triptofanase ela vai quebrar o triptofano em indol e aí o idol não dori saiu daí tô falando do meio de cultura que eu fiz entender um meio enriquecido com triptofano ele quebra
o triptofano indol a partir da ação da triptofanase e aí eu window reagindo com reativo de de eric vai fazer com que o meio é um meio líquido né mas é um meio a fique com esse anel rosa então esse negativo outro aí não tem o anel aqui né rosa que tem um anel rosa ok quando ela é positivo tem um anel quem que é provavelmente aí cole protheus freguesia ela por mim política morganella morgani é só uma a negativa na quer dizer ela pneumonia negativa para o seu domonas negativa proteus mirabilis não é outra
negativo tá então tem algumas bactérias diferença que pode ser reconhecido se separados ó tá vendo que por exemplo são várias positivas então se são várias positivas eu não consigo por este teste dividir essa daqui e não é cada uma de sim pode ser corre pode ser claro se ela pode ser uma organela pode ser deus mas eu tenho outros testes que me separam protheus de acordo então por exemplo se eu voltar aqui né na e tu e aqui por exemplo eu já consigo separar e pode tu dizia ela ah tá já separou ikole de proteus
joão gram-negativo não impede a bom então se eu fiz essa daqui e aí depois eu venho fazer um dó eles se complementam então eu nunca vou resolver as coisas lá o dificilmente eu vou conseguir resolver um diagnóstico o único teste a gente tem uma chave né em que a gente vai colocando isso olha a bactéria é assim assado é assim assado é assim assado então ela deu negativo para isso deu positivo para isso deu positivo a partir de outra da negativa para esse outro e aí de acordo com essa combinação de resultado eu chego à
conclusão de qual bactéria que eu tô trabalhando tá só pra gente vai lembrar gente vamos falar agora um pouquinho então te redução de nitratos tá então a minha bactéria ela tem habilidade na de reduzir o nitrato que vai estar presente em nitrito ou em gás nitrogênio quando ela reduzem nitrito ah eu já sei que isso provavelmente amanhã terei bactéria ah tá quando ela reduza gás que é uma pseudomonas e quando ele não reduz é um acinetobacter tá mas como como funciona o teste tá vamos prestar atenção porque ele é um pouquinho complicado aqui por causa
das cores que podem confundir um pouquinho bom eu tenho lá o meu meio com as minhas bactérias aí eu coloco o reagente na a gente ai eu ver a gente bebê de lissa que vai fazer com que haja essa reação e aí se ele for positivo ele vai ficar vermelho e o quê que significa isso significa que as bactérias reduziram o nitrato a nitrito e aí o nitrito reage com o substrato que eu coloquei na com que a gente que eu coloquei e ele fica vermelho se não tiver o ou seja se a bactéria não
reduziu o nitrato a nitrito ele vai ser negativo ele não vai mudar de cor isso significa que eu nitrato não foi reduzido não pode ser que me trato não tenha sido reduzido mas pode ser que o nitrato tenha sido reduzido a gás nitrogênio e não hálito tá então eu ainda não sei eu ainda não tenho o resultado final do meu teste para isso o que que eu vou fazer eu vou pegar esse tubo aqui nesse primeiro tubo que deu negativo e vou adicionar um pouco de zinco nele o que que o cinco vai fazer o
5 ele vai quebrar o nitrato que tá lá dentro tá em nitrito e fazer com que haja a reação do nitrito com o meu é a gente fazendo com que fique vermelho tá mas quem que quebrou o nitrato nitrito foi a eu não fui 15 tá sim e aqui ficou é transparente não mudou de cor novamente o que que significa significa que não tinha mais nitrato para ser quebrado porque o nitrato já foi quebrado em gás bom então se ele já foi transformado em gás nitrogênio e fez não tem mais nitrato lá para ser quebrado
em nitrito tá então na primeira reação se ficar vermelha positivo significa que reduziu nitrito na segunda reação se ficava vermelho ele é negativo tá significa que não reduziu nada e se ele continuar né depois da segunda reação ele continuar sempre com a cor transparente então significa que ele faz redução a gás nitrogênio ok então esse daqui é entendeu bactéria isso daqui a acinetobacter e esses aqui apareceu donas ok bom então vamos lá mais um teste estamos terminando aí tá agora vamos falar um pouquinho sobre redução de carboidratos tá bom então determinado o cartão do carboidrato
ele pode ser fermentado e originar a partir né deste carboidrato diferentes produtos finais e isso vai depender de química que o organismo está envolvido tá bom então eu tenho micro-organismos que vão produzir um determinado o ácido eu tenho microrganismo que vão produzir gases eu tenho um micro-organismos que vão produzir a sulfato de hidrogénio e cada um deles né me ajuda a identificar esse tipo de bactérias tá bom então eu tenho por exemplo a geração de gases então e-mail líquido eu vou conseguir ver a presença na de cigarro na forma de bolhas no tubo de dura
o tubo de tintura é um o que está em miniatura pequenininho que eu coloco dentro do tubo de ensaio tá então vocês tão vendo ele aqui ele é esse tubinho de ensaio que eu coloco ele de ponta cabeça invertido então esse aqui dentro está produzindo gás parte desse gasto fica preso dentro do tubo e eu consigo ver essa bolha de gás aqui ó então tanto esse daqui quando este daqui são positivos para a produção de gás e esse daqui é negativo esse daqui eu não tenho gasto dentro ok só tem líquido então esse negativo para
gás essa positivo e essa positivo se for em meio sólido né a cão vez aqui em vez de ter um meio líquido tiveram meio sólido eu não uso tudo de dura mas eu vejo a quebra do meio ou deslocamento do meio de cultura então esse meio ele encaixa tá ou ele vai se separar da parede do tubo se o meio for sólido ok oi e a outra coisa que a gente pode avaliar a geração de ácidos orgânicos estão podem ser detectados pela mudança de cor não é do indicador então eu vou ter diferentes indicadores que
vão me deixar a nossa coloração amarela coloração vermelha coração emagreci vida de acordo com a o tipo de açúcar ou de carboidrato na idade que foi quebrado o tipo de ácido que ele forma etc ok serve para diferenciar né bacilos gram-negativos com base na fermentação de carboidratos ou produção de sulfato de hidrogénio na e a produção de gás sulfato de hidrogénio e também a gastar vamos lá aqui a gente tá vendo esse e-mail vou ter uma fotinho melhor para a gente se ver tá bom normalmente um mês o que vai aqui dentro é esse psi
tá céu trecho girl airon tá três açúcares e ferro tá o teste chama ele pouco sugarhai um ok então aqui está o meio triplo iron quando eu coloco ele fica desse jeito nessa cor ok e aí coloquei vou lá inocula a minha bactéria depois de um tempo determinado eu vou ver qual são as reações que as minhas bactérias tem ok então por exemplo se mudou tudo de cor essa ponta aqui a gente vai ver nesta tabela e isso ele chama deslant tá que é a inclinação está inclinado o boot seria um fundo tá então essa
região aqui é o banshee um ok aí a produção de gás olha que algo que produzir o gás tá vendo aqui tá separado do fundo aqui aqui porque produzir o gás tá e quando produz o seu sofrendo ou sulfato desculpa agora eu sulfato de hidrogénio perdão o sulfato de hidrogénio quando ele é produzido ele vai dar esta minha certa sumiu ele vai dar aqui essa cor que nem agressiva o ok então vamos lá e aí de acordo com a combinação disso eu vou avaliando a minha bactéria então vamos pegar aqui por exemplo aí cole aí
cole eu sei que ela vai ter a a internação amarelada o fundo amarelado é todo amarelado ele é positiva pagar mas ele é negativo para produção de sulfato de hidrogénio olha só amarelo amarelo eu vejo aqui galo tá muito bonito mas parece ter um deslocamento e rachaduras no meu mei tá então tem produção de gás mas ele não tá enegrecido então não tem a produção então esse aqui é um típico é triple triple super airon para nicole ser um resultado característica de e cole e quem seu coloca aqui vermelho vermelho né sem presença de gás
em presença de sulfato de hidrogénio isso é característico da seu domonas aeruginosa bom se eu pegar aqui vamos lá salmonella paratyphi luz lentes e ela o exame red é um vermelho pote é lou tem produção de gás ou passa em produção de gás e eu falei salmonella paratyphi né e sem produção de ácido sulfídrico então é esse daqui característica desse aqui ó vermelho amarelo com produção de gás e sem a produção de ácido sulfúrico eu sou manuela typhimurium que é outra né outra espécie aqui então ele vai ser vermelho e ele pode amarelo neve seria
maré sei lá ser amarelo tem produção de gás tá só que produz a sophie hídrico e isso daqui atingiu a parte amarela que a gente não consegue ver tá mas esse daqui seria o característica então de uma salmonella tá bom claro que tem bactérias aqui se você olhar e os eu não me engano proteus vulgaris oi e a salmonella typhi elas são iguais e assim como as soft manoela para tiff é para te fi não é mas você tem combinações aqui obviamente que podem ser semelhantes tá então mesmo este exame que dessa várias coisas ao
mesmo tempo não dá conta de resolver todos os nossos problemas sozinho tá então eu teria que fazer alguma coisa tem que ter um outro exame para separar por exemplo o meu protheus da minha salvar nela que que eu posso fazer posso voltar lá trás e fazer um teste que vai avaliar para mim a diferença de bactérias que são histéricas na são bacilos gram-negativos não fermentadores ou não histéricos dos internos então por exemplo na verdade eu poderia fazer o vermelho de metila e aí ah tá e por exemplo 1 e aí bom então gente é isso
tá a isso aqui realmente era para dar uma ideia geral de como se faz para fazer o diagnóstico não é bacteriano então basicamente o que a gente vai usar na microbiologia são esses pedientes é claro que hoje né a gente pode acoplar ao cardápio né ou ao escopo aí de testes uma série de novos testes de testes na cidade de biologia molecular e outras e outras técnicas que nos ajudam na a ter um diagnóstico cada dia mais preciso mais basicamente na dentro da nossa microbiologia clássica aqui a gente vai trabalhar com essa questão do uso
dos meios de é um o uso dos testes bioquímicos para chegar a um diagnóstico na de bactérias agora a gente cada dia mais estar se aprofundando então às vezes não me interessa mais saber que bactéria aquela eu preciso saber qual é a sua cepa qual é o seu sorovar né então se a gente tiver falando por exemplo de leptospiras mas isso a gente vai falar lá na frente para a gente falar especificamente de leptospirose eu tenho que diferenciar qual é a minha leptospira ah mas é um gênero que eu assim mas todas as leptospiras né
que causam doenças são leptospiras em rodas oi e aí todas são enterradas mas quem que está atuando é a comuna é a canícula aí kit muhaj cada uma delas tem uma ação diferente no organismo e em organismos diferentes então aí tinha o raj causa uma lesão no cão e a canícula não causa e vice-versa então a gente tem que conseguir diferenciar para tudo isso são técnicas cada vez mais avançadas e cada vez mais complexas né para gente conseguir chegar isso tudo isso existe tá mas não entra no escopo aqui do que a gente precisa para
essa disciplina gente é isso eu espero que tenha sido bastante útil para vocês tá bom um grande abraço a todos se como hoje é o dia do trabalho né eu espero o dia do trabalhador na verdade eu espero que oi tem almoço aí trabalhadores muito felizes e trabalhadores que dia a dia não estejam mais amparados pelo nosso poder público e é isso um abraço
Related Videos

19:41
Provas bioquímicas para identificação de E...
Morfo Rangers
11,702 views

47:16
Microbiologia - Meios de Cultura
Camila de Souza
6,242 views

7:57
Coagulase Test
Rejo Jacob Joseph
23,149 views

36:10
Meios de cultura
Eduardo Garrido
889 views

1:20:02
Série Bioquímica de identificação para bac...
Canal do Residente Biomédico
6,571 views

45:10
Shree Hanuman chalisa श्रीराम #श्री हनुमान...
Rishabh
31,136,218 views

8:22
PROVAS BIOQUÍMICAS - CITRATO, UREIA, SIM E...
Biomedicina da zoeira
39,830 views

1:18:37
Provas de identificação bactérias gram neg...
Professora Nathália Abreu
8,546 views

56:33
Provas Bioquímicas para Identificação de e...
Professor Gladson Carvalho
3,632 views

29:42
VÍRUS - MICROBIOLOGIA - AULA | Biologia co...
Biologia com Samuel Cunha
1,795,756 views

27:12
Identificação bacteriana do começo ao fim
Laboratório Microanálises - Viviane Castro
4,027 views

55:43
Palestra - "Identificação Bacteriana"
Conselho Regional de Farmácia do Estado do Paraná
48,247 views

37:47
Microbiologia - Bactérias
CCBS
91,569 views

12:51
Testes bioquímicos - O/F Glic, TSI, Ferm. ...
Hudson Holanda
2,884 views

14:39
Provas Bioquímicas
Gabrielle França Ribeiro
4,904 views

1:18:12
Provas de identificação cocos gram positivos
Professora Nathália Abreu
4,114 views

1:02:04
Microbiologia Médica: Introdução aos Bacil...
CS Ciências da Saúde
43,228 views

23:37
Coloração de Gram - Aula completa - Prof. ...
Felipe Magalhães
54,180 views

40:32
Microbiologia Médica: Principais Meios de ...
CS Ciências da Saúde
26,964 views
16:47
Unidade 4 - Vídeo 3 - Cultivo e cresciment...
Mirian Niz
16 views